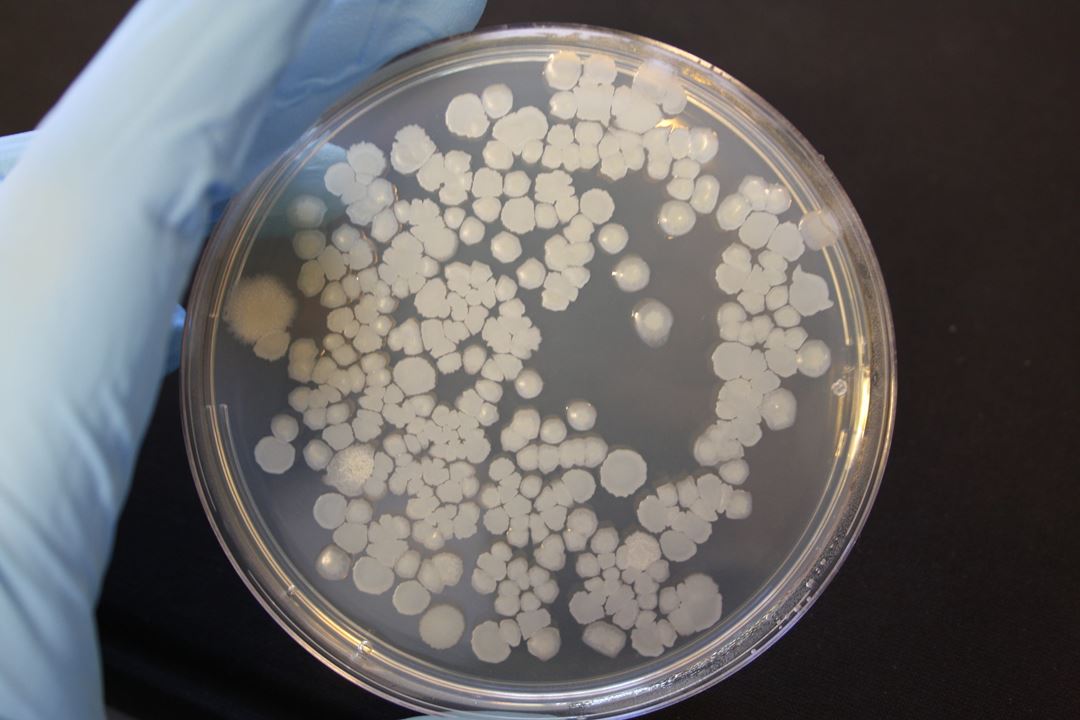

Our laboratory staff have high levels of expertise in the field of microbial research and development. We apply both standard methods and specially-tailored approaches in close collaboration with our clients.
The laboratory utilises the Laboratory Information Management System (LIMS) in order to meet stringent requirements linked to the quality of documentation and reporting.
We offer the following analyses:
Molecular biological methods
- Metagenomic analysis
- Extraction of DNA/RNA from different matrices
- PCR/Real-time PCR
- Electrophoresis
- DGGE
- Cloning and sequencing
Microbiological methods
- Determinations of heterotrophic and oil-degrading bacteria using statistical incubation methods (MPN)
- Sulphate-reducing bacteria (SRB)
- Fluorescence microscopy
- Cultivation of aerobic and anaerobic microorganisms under different environmental conditions
- Bio-film analyses
- Biodegradation studies
Medical microbiology
Communities are facing an ever-increasing problem of infectious diseases resulting from exposure to infection hazards in water and the environment. We have built up our expertise and developed diagnostic tools for the monitoring and prevention of environmentally-related infections.
We run a well-established and well-equipped laboratory in which we carry out analyses to identify infectious environmental bacteria, in particular Legionella pneumophila, Pseudomonas aeruginosa and coliform bacteria, as well as other environmental pathogens such as amoebae and parasites.
We offer the following analyses:
- The detection and diagnosis of Legionella pneumophila, free-living amoebae and other microorganisms in water and environmental samples.
- DNA and RNA extraction
- Genetic analyses (Real-time PCR)
- Cultivation
- Microscopy
- Epidemiological investigations in connection with infection outbreaks, and source tracing (PFGE and RAPD)
- Identification of bacteria with the aid of MALDI-TOF mass spectrometry
- Parasite analyses in water and environmental samples (Cryptosporidium and Giardia)
- Risk assessment of water systems